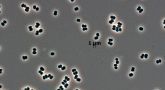

5/2020 (79) сентябрь-октябрь
- КВАРТАЛЬНЫЕ СОБЫТИЯ
- Аналитика Экспо 2020

С 22 по 25 сентября 2020 года в Москве в МВЦ «Крокус Экспо» с успехом прошла 18-я Международная выставка лабораторного оборудования и химических реактивов ≪Аналитика Экспо≫.
Более 100 российских и зарубежных компаний представили свою продукцию профессиональным посетителям из фармацевтической, химической, пищевой, нефтегазовой, металлургической и других отраслей промышленности.
- ЧИСТЫЕ ПОМЕЩЕНИЯ
- Кондиционирование воздуха на практике Как системы воздухоподготовки могут быть источником значительного снижения расхода средств и выбросов углекислого газа

Если бы вы могли снизить выбросы CO2 на 1000 тонн и сэкономить тысячи долларов ежегодно, повысив надёжность вашей лаборатории, Вы бы сделали это?
- ЧИСТЫЙ БАРЬЕР
- Очистка и дезинфекция помещений с помощью аэрозолей и/или тумана дезинфицирующих средств

Очистке и дезинфекции после производственного процесса подвергаются только поверхности, контактирующие с пищевыми продуктами, что может привести к выживанию микроорганизмов в производственной среде в целом.
- Проблемы выполнения процедуры очистки

Специалисты по валидации и качеству выявили целый ряд проблем с ручной очисткой фармацевтического производственного оборудования. В данной статье представлены актуальные проблемы с корректирующими и предупреждающими действиями (Corrective and Preventive Actions, CAPA).
- Минимизация выживания микроорганизмов на поверхностях чистых помещений
Мониторинг микробиологической чистоты в чистых помещениях в основном проводят в соответствии со стандартами – с использованием культивации, контактных пластин или ватных палочек. Хорошо известно, что методы мониторинга производственной среды ограничены в своей способности восстанавливать микроорганизмы с поверхности из-за ограничений самих методов, селективности питательных сред и времени инкубации, а также из-за сложностей, связанных с поверхностным сцеплением микроорганизмов, присутствия активных, но не пригодных для культивации микроорганизмов.
- ИНЖЕНЕРНАЯ ПРАКТИКА
- Проектирование, квалификация и эксплуатация мощностей для производства лекарственных средств, содержащих опасные вещества

В соответствии с ключевым принципом, изложенным в Главе 1 Правил надлежащей производственной практики [1], «производитель должен производить лекарственные средства таким образом, чтобы гарантировать их соответствие своему назначению, требованиям регистрационного досье и (или) протоколу клинического исследования и минимизировать риск для пациентов, связанный с безопасностью, качеством и эффективностью лекарственных средств»...
- Квалификация чистых помещений для производства нестерильных лекарственных средств согласно серии технических отчетов ВОЗ

Основные требования к чистым помещениям изложены в Приложении 1 GMP [3], [4], [5], [6] «Требования к производству стерильных лекарственных средств» [6]. Именно это приложение вводит для помещений и зон пресловутые классы чистоты A, B, C и D (хотя американцы превосходно обходятся классами ISO 5, 7, 8)...













